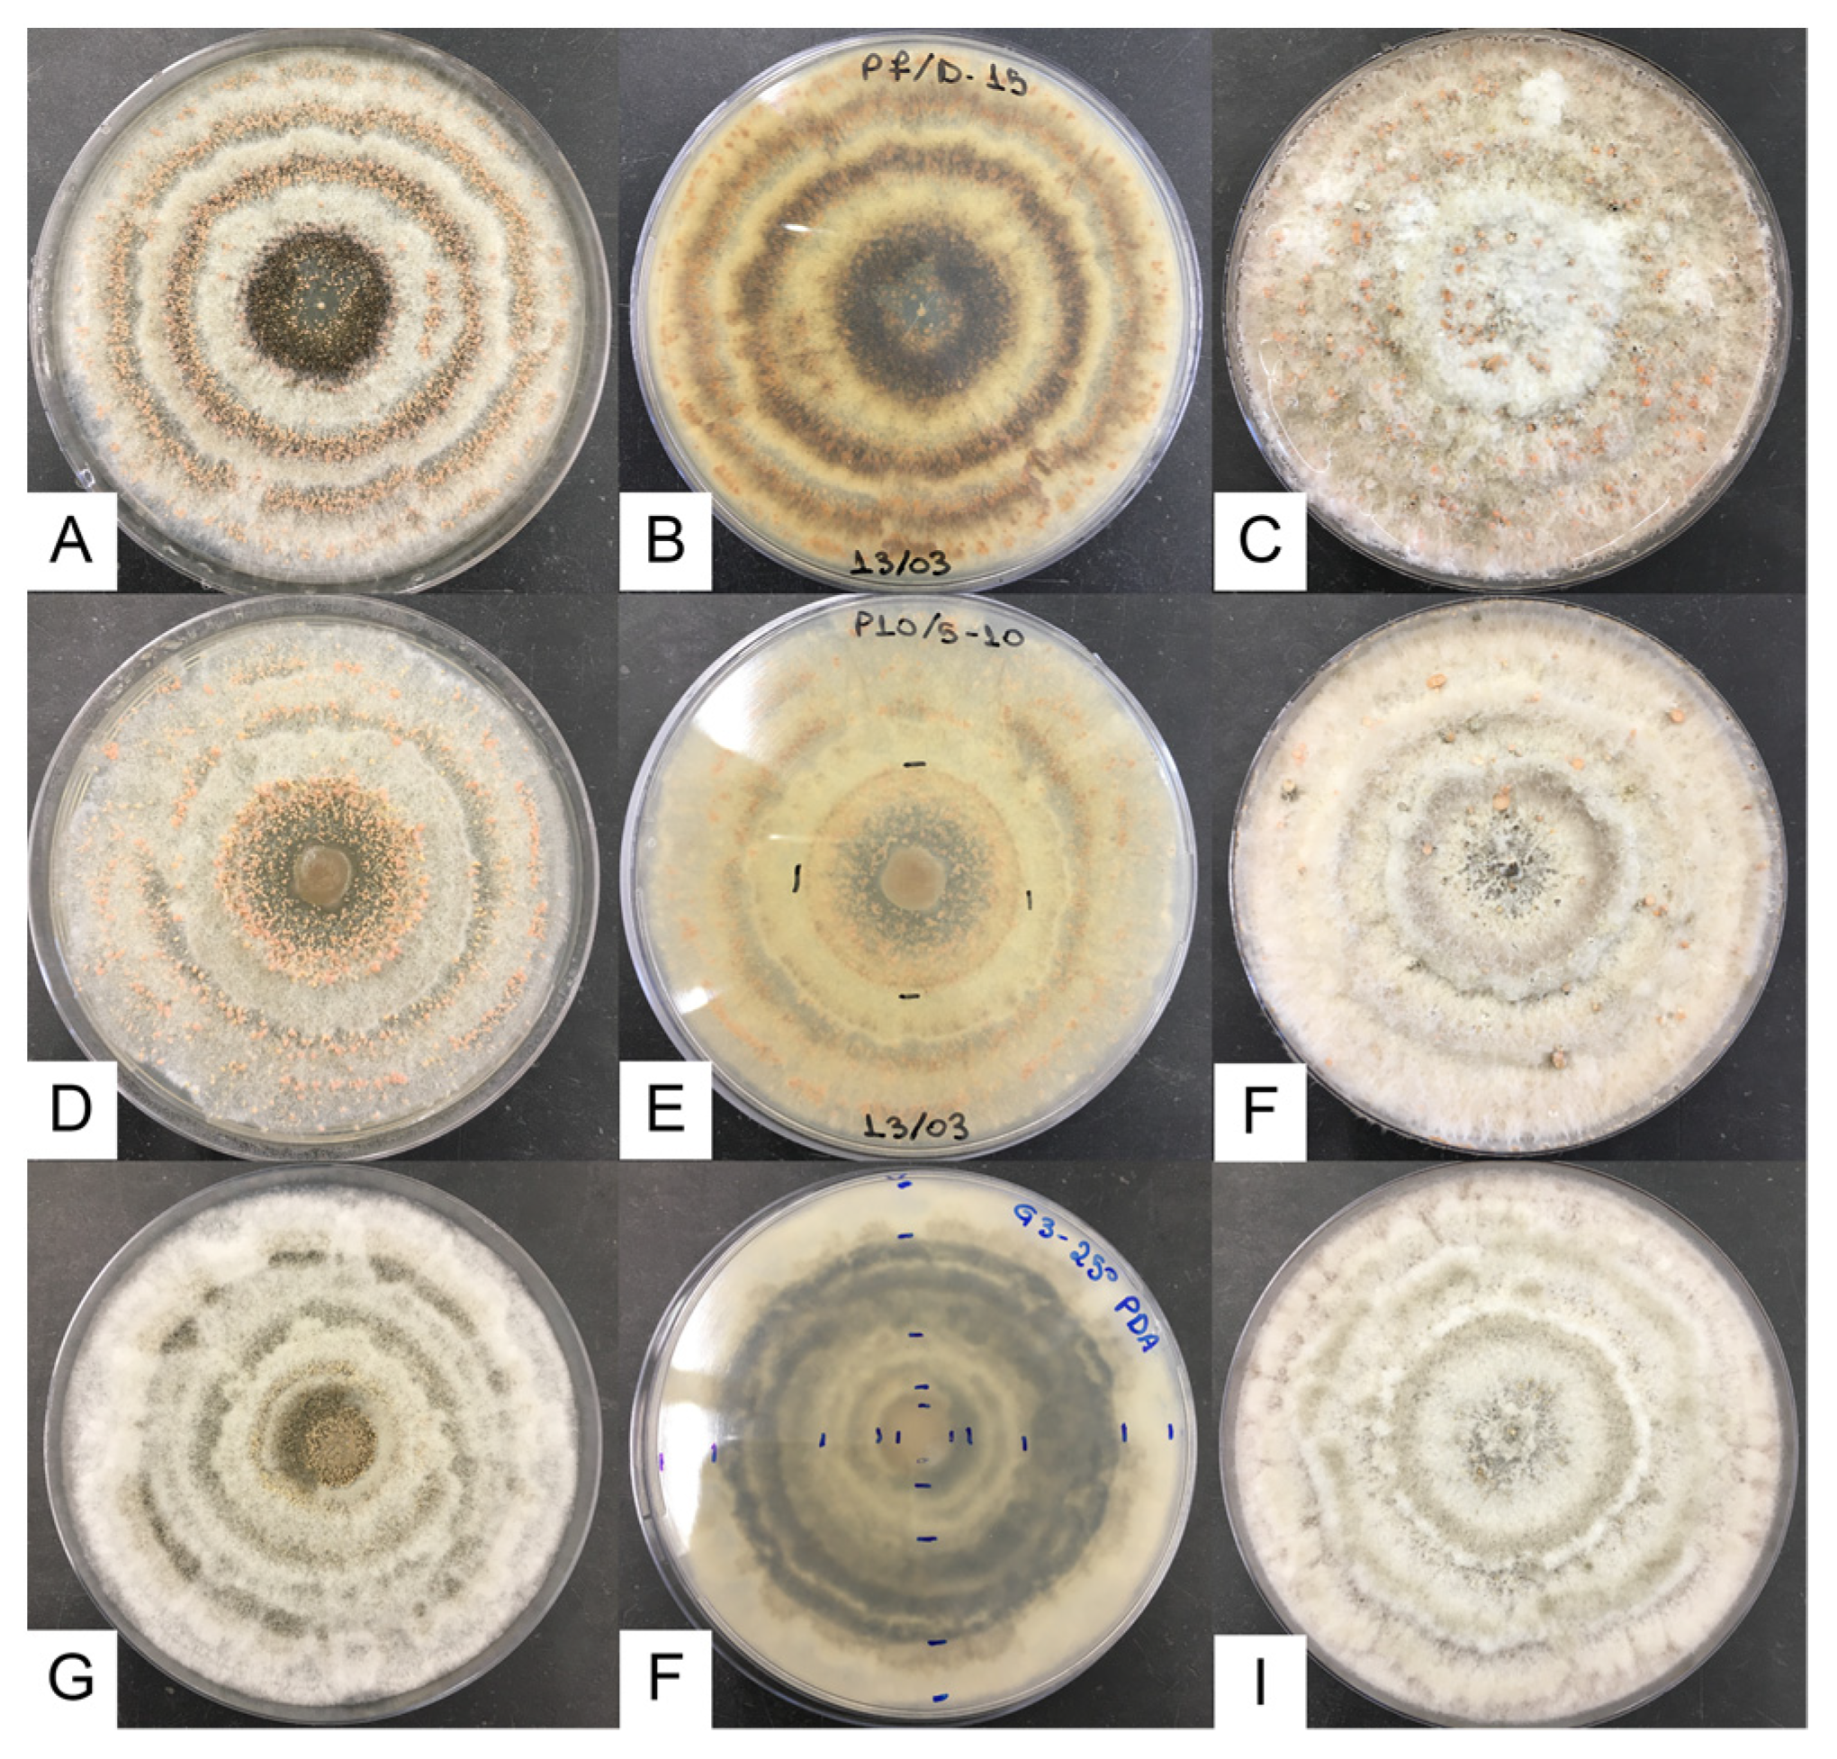
Jof 09 00401 g002
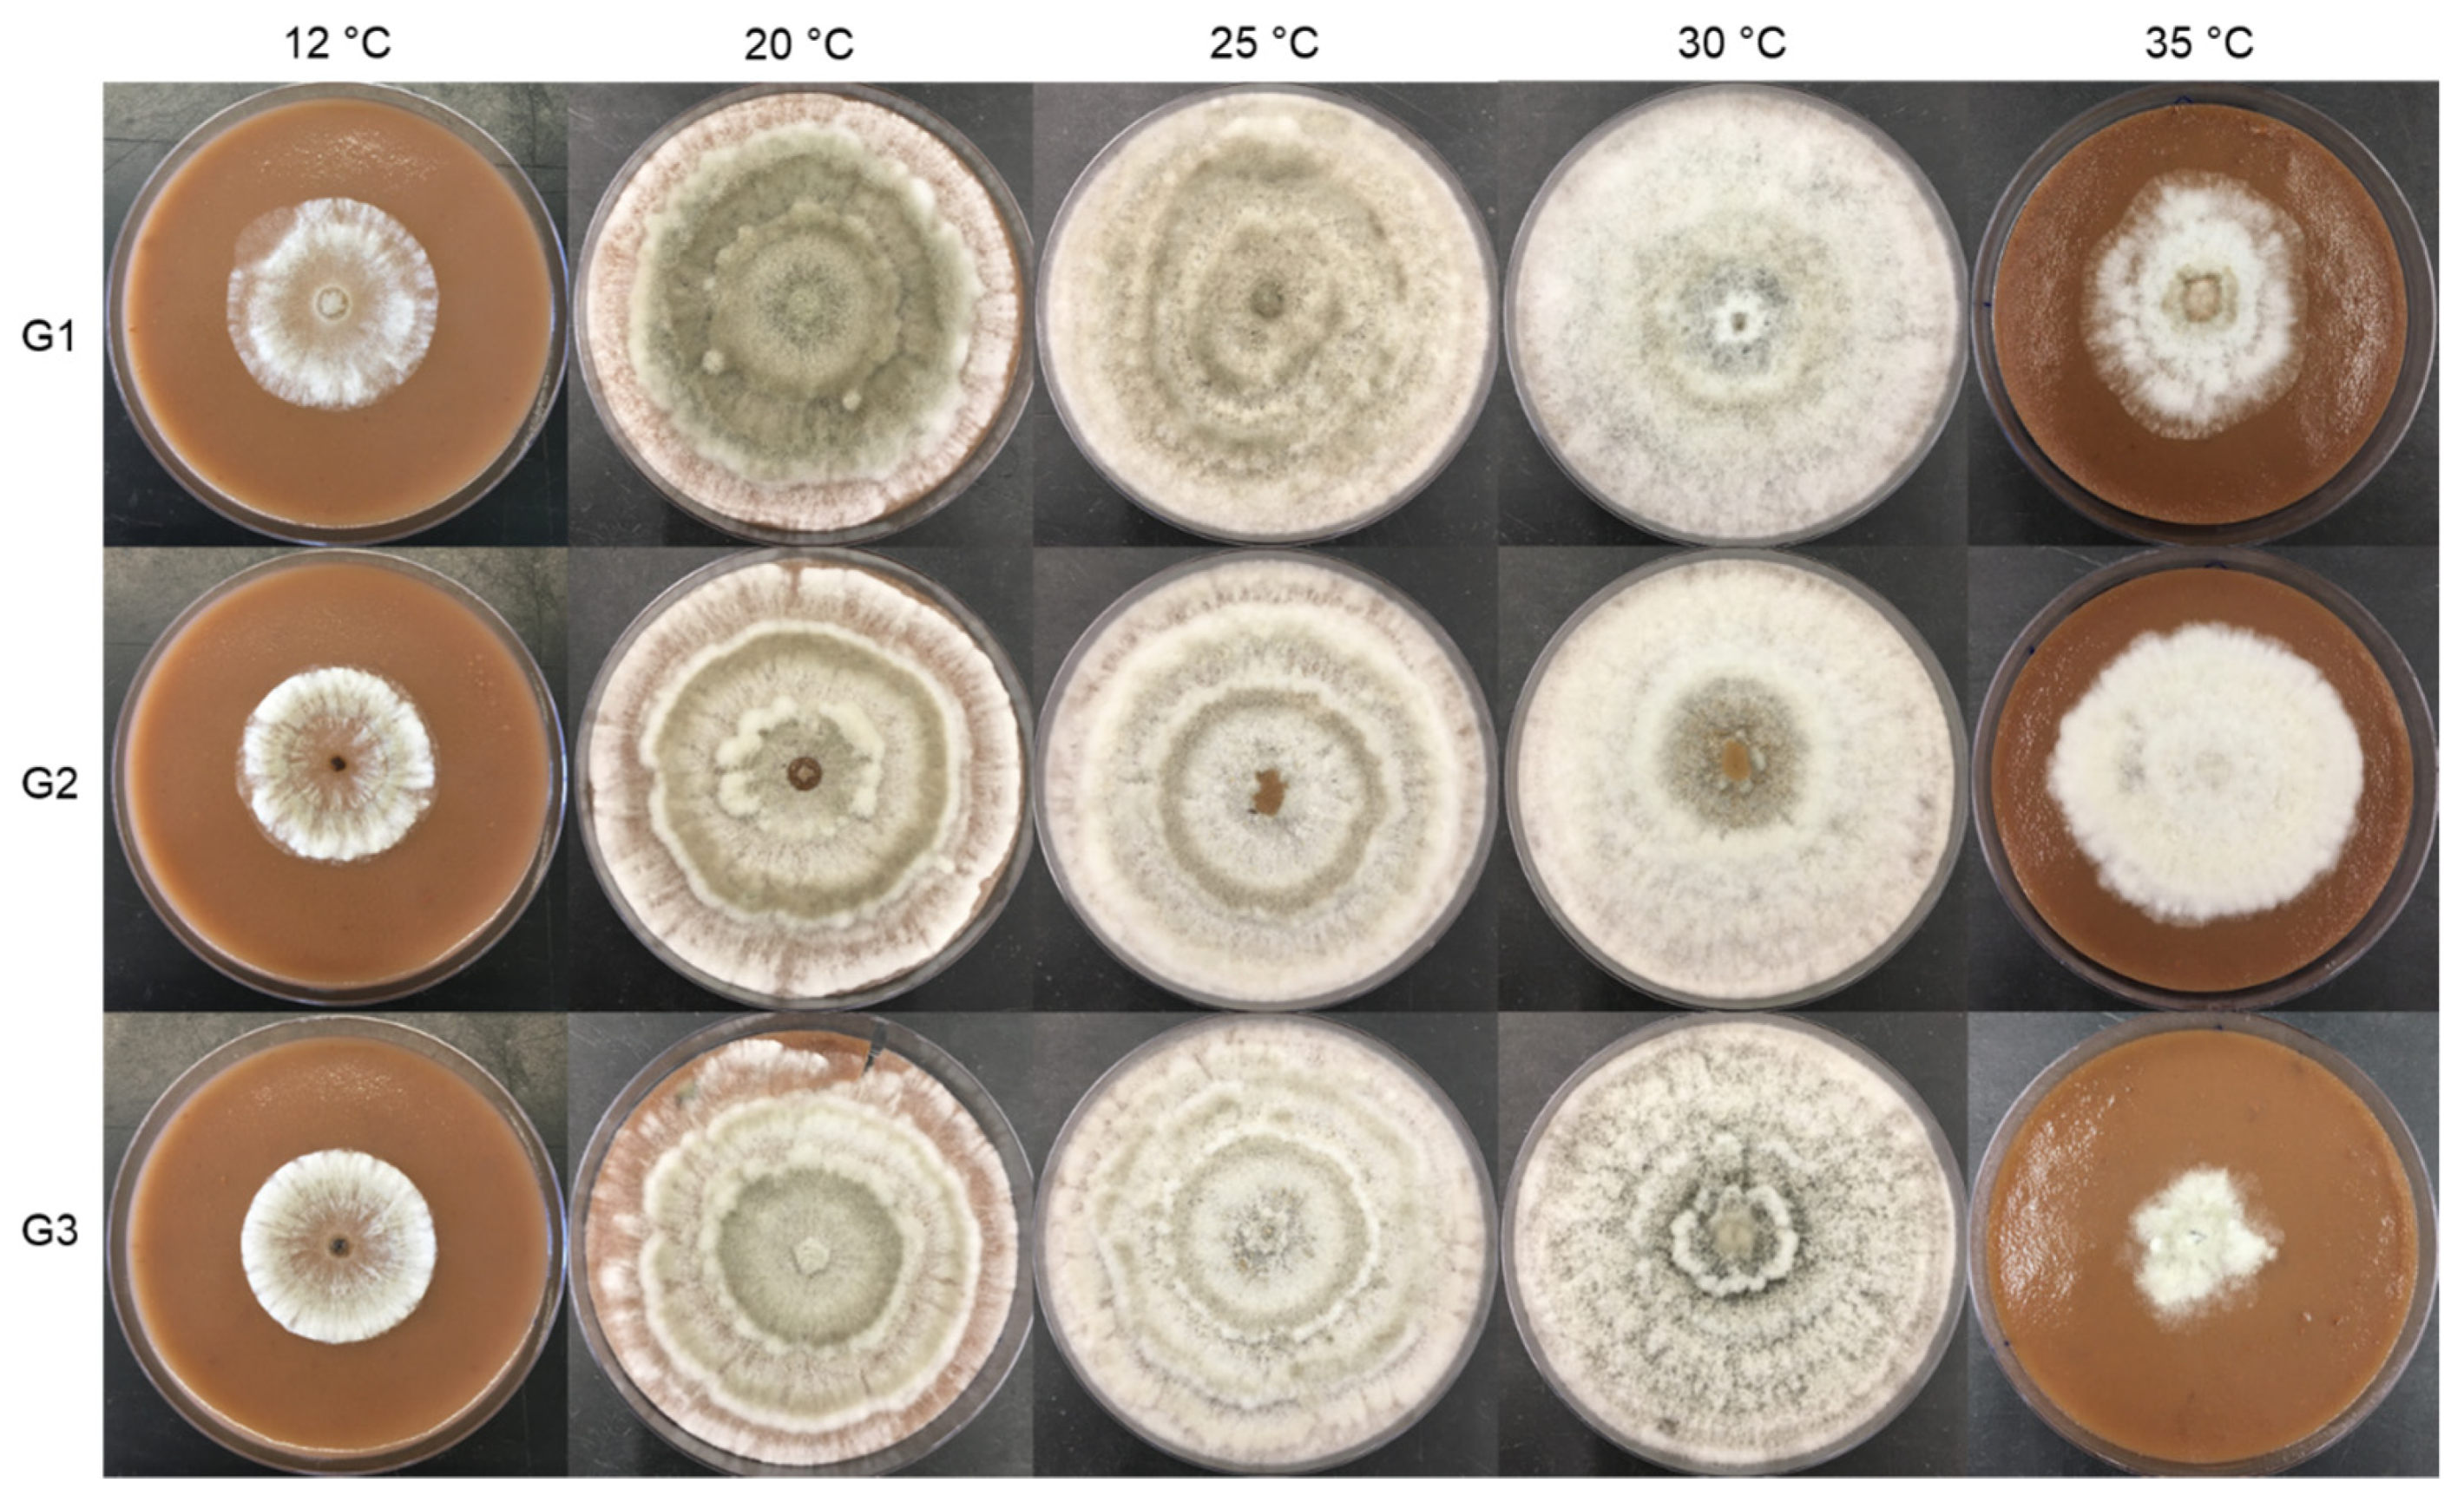
Jof 09 00401 g005

Chestnut Brown Rot and Gnomoniopsis smithogilvyi: Characterization of the Causal Agent in Portugal
Abstract
1. Introduction
2. Materials and Methods
2.1. Biological Material
2.2. Tests of Pathogenicity and Virulence of G. smithogilvyi Isolates
2.2.1. Preparation of Chestnuts
2.2.2. Preparation of Spore Suspensions
2.2.3. Inoculation and Incubation
2.2.4. Evaluation of Infection Rate in Chestnuts Inoculated with G. smithogilvyi
2.2.5. Verification of Koch’s Postulates
2.3. Natural Incidence of G. smithogilvyi in Chestnuts
2.4. Morphological and Cultural Characterization of the Isolates
2.4.1. Biological Material and Culture Media
2.4.2. Inoculation and Growth Parameters
2.4.3. Measurement of Conidia and Conidiomata
2.5. Molecular Characterization of the Isolates
2.6. Statistical Analysis
3. Results
3.1. Natural Incidence of G. smithogilvyi in Chestnuts
3.2. Tests of Pathogenicity and Virulence of G. smithogilvyi Isolates
3.3. Morphology and Ecophysiology of G. smithogilvyi
3.4. Molecular Characterization
4. Discussion
Author Contributions
Funding
Institutional Review Board Statement
Informed Consent Statement
Data Availability Statement
Conflicts of Interest
References
- Vasconcelos, M.C.B.M.; Bennett, R.N.; Rosa, E.A.S.; Ferreira-Cardoso, J.V. Composition of European chestnut (Castanea sativa Mill.) and association with health effects: Fresh and processed products. J. Sci. Food Agric. 2010, 90, 1578–1589. [Google Scholar] [CrossRef] [PubMed]
- FAO. Food and Agriculture Organization of the United Nations (FAO), Production of Chestnut by Countries, Statistics Division. 2022. Available online: https://www.fao.org/faostat/en/#home (accessed on 15 September 2022).
- INE. Estatísticas Agrícolas 2020; Instituto Nacional de Estatística: Lisbon, Portugal, 2021. [Google Scholar]
- Matos, A. O Sistema de Comercialização de Castanha da Terra Fria Transmontana e Sua Cadeia de Valor. Master’s Dissertation, Universidade de Trás-os-Montes e Alto Douro, Vila Real, Portugal, 2003. Available online: http://hdl.handle.net/10198/930 (accessed on 13 December 2022).
- Gomes-Laranjo, J.; Ferreira-Cardoso, J.; Portela, E.; Abreu, C.G. Castanheiros; Universidade de Trás-os-Montes e Alto Douro: Vila Real, Portugal, 2007; ISBN 978-972-669-844-9. [Google Scholar]
- Smith, H.C.; Ogilvy, D. Nut rot in chestnuts. Austral. Nutgrow. 2008, 2, 10–15. [Google Scholar]
- Smith, H.C.; Agri, M. The life cycle, pathology, and taxonomy of two different nut rot fungi in chestnut. Austral. Nutgrow. 2008, 22, 11–15. [Google Scholar]
- Gentile, S.; Valentino, D.; Visentin, I.; Tamietti, G. Discula pascoe infections of sweet chestnut fruits in North-West Italy. Austral. Nutgrow. 2009, 23, 23–25. [Google Scholar]
- Visentin, I.; Gentile, S.; Valentino, D.; Gonthier, P.; Tamietti, G.; Cardinale, F. Gnomoniopsis castanea sp. nov. (Gnomoniaceae, Diaporthales) as a causal agent of nut rot in sweet chestnut. J. Plant Pathol. 2012, 94, 411–419. [Google Scholar]
- Shuttleworth, L.A.; Liew, E.C.Y.; Guest, D.I. Survey of the incidence of chestnut rot in south-eastern Australia. Australas. Plant Pathol. 2013, 42, 63–72. [Google Scholar] [CrossRef]
- Shuttleworth, L.A.; Guest, D.I.; Liew, E.C.Y. Fungal Planet Description Sheet 107: Gnomoniopsis smithogilvyi. Persoonia 2012, 28, 142–143. [Google Scholar] [CrossRef]
- Shuttleworth, L.A.; Guest, D.I. The infection process of chestnut rot, an important disease caused by Gnomoniopsis smithogilvyi (Gnomoniaceae, Diaporthales) in Oceania and Europe. Australas. Plant Pathol. 2017, 46, 397–405. [Google Scholar] [CrossRef]
- Dar, M.A.; Rai, M.K. Gnomoniopsis smithogilvyi a canker causing pathogen on Castanea sativa: First report. Mycosphere 2015, 6, 327–336. [Google Scholar] [CrossRef]
- Lione, G.; Giordano, L.; Sillo, F.; Brescia, F.; Gonthier, P. Temporal and spatial propagule deposition patterns of the emerging fungal pathogen of chestnut Gnomoniopsis castaneae in orchards of north-western Italy. Plant Pathol. 2021, 70, 2016–2033. [Google Scholar] [CrossRef]
- Maresi, G.; Oliveira Longa, C.M.; Turchetti, T. Brown rot on nuts of Castanea sativa Mill: An emerging disease and its causal agent. iForest 2013, 6, 294–301. [Google Scholar] [CrossRef]
- Dennert, F.G.; Broggini, G.A.L.; Gessler, C.; Storari, M. Gnomoniopsis castanea is the main agent of chestnut nut rot in Switzerland. Phytopathol. Mediterr. 2015, 54, 41–53. [Google Scholar]
- Lewis, A.; Gorton, C.; Rees, H.; Webber, J.; Perez-Sierra, A. First report of Gnomoniopsis smithogilvyi causing lesions and cankers of sweet chestnut in the United Kingdom. New Dis. Rep. 2017, 35, 20. [Google Scholar] [CrossRef]
- Sakalidis, M.L.; Fulbright, D.W.; Kolp, M.; Medina Mora, C. First report of Gnomoniopsis smithogilvyi causing chestnut brown rot on chestnut fruit in Michigan. Plant Dis. 2019, 103, 2134. [Google Scholar] [CrossRef]
- Cisterna-Oyarce, V.; Carrasco-Fernández, J.; Castro, J.F.; Santelices, C.; Muñoz-Reyes, V.; Millas, P.; Buddie, A.G.; France, F. Gnomoniopsis smithogilvyi: Identification, characterization and incidence of the main pathogen causing brown rot in postharvest sweet chestnut fruits (Castanea sativa) in Chile. Australas. Plant Dis. Notes 2022, 7, 2. [Google Scholar] [CrossRef]
- Aguín, O.; Rial, C.; Piñón, P.; Sainz, M.J.; Mansilla, J.P.; Salinero, C. First report of Gnomoniopsis smithogilvyi causing chestnut brown rot on nuts and burrs of sweet chestnut in Spain. Plant Dis. 2023, 107, 218. [Google Scholar] [CrossRef]
- O’Loinsigh, B.; McAuley, D.; Bréchon, A.L.; Lopez Vernaza, M.; Ryan, C.; Destefanis, M.L.; O’Hanlon, R. First report of the fungus Gnomoniopsis smithogilvyi causing cankers on sweet chestnut (Castanea sativa) in Ireland. New Dis. Rep. 2022, 45, e12072. [Google Scholar] [CrossRef]
- Çakar, D.; Şimşek, S.A. First report of Gnomoniopsis smithogilvyi causing nut rot on Castanea sativa in Turkey. New Dis. Rep. 2022, 46, e12105. [Google Scholar] [CrossRef]
- Coelho, V.; Gouveia, E. Fungos associados com as podridões da castanha. In I Congresso Luso-Brasileiro de Horticultura; Associação Portuguesa de Horticultura: Lisbon, Portugal, 2017; p. 162. [Google Scholar]
- Coelho, V.; Gouveia, E. Gnomoniopsis smithogilvyi, the causal agent of chestnut brown rot reported from Portugal. New Dis. Rep. 2021, 43, e12007. [Google Scholar] [CrossRef]
- Rodrigues, P.; Driss, J.O.; Gomes-Laranjo, J.; Sampaio, A. impact of cultivar, processing and storage on the mycobiota of european chestnut fruits. Agriculture 2022, 12, 1930. [Google Scholar] [CrossRef]
- Donis-González, I.R.; Guyer, D.E.; Fulbright, D.W. Quantification and identification of microorganisms found on shell and kernel of fresh edible chestnuts in Michigan. J. Sci. Food Agric. 2016, 96, 4514–4522. [Google Scholar] [CrossRef] [PubMed]
- McKinney, H.H. Influence of soil temperature and moisture on infection of wheat seedlings by Helminthosporium sativum. J. Agric. Res. 1923, 26, 195–218. [Google Scholar]
- Rodrigues, P.; Venâncio, A.; Lima, N. Toxic reagents and expensive equipment: Are they really necessary for the extraction of good quality fungal DNA? Lett. Appl. Microbiol. 2018, 66, 32–37. [Google Scholar] [CrossRef]
- White, T.J.; Bruns, T.; Lee, S.; Taylor, J. Amplification and Direct Sequencing of Fungal Ribosomal RNA Genes for Phylogenetics. In PCR Protocols; Elsevier: Amsterdam, The Netherlands, 1990; pp. 315–322. [Google Scholar] [CrossRef]
- Carbone, I.; Kohn, L.M. A method for designing primer sets for speciation studies in filamentous ascomycetes. Mycologia 1999, 91, 553–556. [Google Scholar] [CrossRef]
- Rehner, S.A.; Buckley, E. A Beauveria phylogeny inferred from nuclear ITS and EF1-α sequences: Evidence for cryptic diversification and links to Cordyceps teleomorphs. Mycologia 2005, 97, 84–98. [Google Scholar] [CrossRef] [PubMed]
- Thompson, J.D.; Gibson, T.J.; Plewniak, F.; Jeanmougin, F.; Higgins, D.G. The CLUSTAL_X windows interface: Flexible strategies for multiple sequence alignment aided by quality analysis tools. Nucleic Acids Res. 1997, 25, 4876–4882. [Google Scholar] [CrossRef]
- Tamura, K.; Stecher, G.; Kumar, S. MEGA11: Molecular Evolutionary Genetics Analysis version 11. Mol. Biol. Evol. 2021, 38, 3022–3027. [Google Scholar] [CrossRef]
- Saitou, N.; Nei, M. The neighbor-joining method: A new method for reconstructing phylogenetic trees. Mol. Biol. Evol. 1987, 4, 406–425. [Google Scholar]
- Jukes, T.H.; Cantor, C.R. Evolution of protein molecules. In Mammalian Protein Metabolism; Academic Press: New York, NY, USA, 1969; pp. 21–132. [Google Scholar] [CrossRef]
- Tamura, K.; Nei, M.; Kumar, S. Prospects for inferring very large phylogenies by using the neighbor-joining method. PNAS 2004, 101, 11030–11035. [Google Scholar] [CrossRef] [PubMed]
- Turco, S.; Bastianelli, G.; Morales-Rodrìguez, C.; Vannini, A.; Mazzaglia, A. development of a TaqMan qPCR assay for the detection and quantification of Gnomoniopsis castaneae in chestnut tissues. Forest Pathol. 2021, 51, e12701. [Google Scholar] [CrossRef]
- Bastianelli, G.; Morales-Rodríguez, C.; Caccia, R.; Turco, S.; Rossini, L.; Mazzaglia, A.; Thomidis, T.; Vannini, A. Use of phosphonate salts to control chestnut ‘brown rot’ by Gnomoniopsis castaneae in fruit orchards of Castanea sativa. Agronomy 2022, 12, 2434. [Google Scholar] [CrossRef]
- Silva-Campos, M.; Islam, M.T.; Cahill, D.M. Fungicide control of Gnomoniopsis smithogilvyi, causal agent of chestnut rot in Australia. Australas. Plant Pathol. 2022, 51, 483–494. [Google Scholar] [CrossRef]
- Silva-Campos, M.; Nadiminti, P.; Cahill, D. Rapid and accurate detection of Gnomoniopsis smithogilvyi the causal agent of chestnut rot, through an internally controlled multiplex PCR assay. Pathogens 2022, 11, 907. [Google Scholar] [CrossRef]
- Cuamba, M.U. Importância dos fatores bióticos (pragas e doenças) em pré-colheita na qualidade e conservação da castanha. Master’s Dissertation, Instituto Politécnico de Bragança, Bragança, Portugal, 2020. Available online: http://hdl.handle.net/10198/21803 (accessed on 15 December 2022).
- Sogonov, M.V.; Castlebury, L.A.; Rossman, A.Y.; Mejía, L.C.; White, J.F. Leaf-inhabiting genera of the Gnomoniaceae, Diaporthales. Stud. Mycol. 2008, 62, 1–77. [Google Scholar] [CrossRef] [PubMed]
- Shuttleworth, L.A.; Walker, D.M.; Guest, D.I. The chestnut pathogen Gnomoniopsis smithogilvyi (Gnomoniaceae, Diaporthales) and its synonyms. Mycotaxon 2015, 130, 929–940. [Google Scholar] [CrossRef]
- Trapiello, E.; Feito, I.; González, A.J. First report of Gnomoniopsis castaneae causing canker on hybrid plants of Castanea sativa × C. crenata in Spain. Plant Dis. 2018, 102, 1040. [Google Scholar] [CrossRef]

| Incidence (%) | Severity | |||||
|---|---|---|---|---|---|---|
| Treatment | Longal | Judia | Martaínha | Longal | Judia | Martaínha |
| Cut (7 days) | 56 ± 38 | 44 ± 38 | 33 ± 33 | 0.14 | 0.08 | 0.08 |
| Intact (7 days) | 22 ± 38 | 11 ± 19 | 11 ± 19 | 0.06 | 0.03 | 0.03 |
| Intact (14 days) | 11 ± 19 | 11 ± 19 | 22 ± 19 | 0.03 | 0.03 | 0.08 |
| Intact (21 days) | 11 ± 19 | 22 ± 19 | 0 | 0.03 | 0.14 | 0.00 |
| Incidence (%) | Severity | ||||||
|---|---|---|---|---|---|---|---|
| Isolate | Type of Inoculation | Longal | Judia | Martaínha | Longal | Judia | Martaínha |
| Not inoculated | Cut | 0 a | 0 a | 17 a | 0.00 a | 0.00 a | 0.17 b |
| Perforated | 50 b | 17 a | 50 b | 0.29 c | 0.08 a | 0.25 b | |
| Intact | 33 b | 17 a | 0 a | 0.13 b | 0.04 a | 0.00 a | |
| G1 | Cut | 100 a | 100 a | 100 a | 0.83 a | 1.00 a | 0.83 a |
| Perforated | 100 a | 100 a | 100 a | 1.00 a | 0.92 a | 0.67 a | |
| Intact | 50 b | 17 b | 0 b | 0.20 b | 0.04 b | 0.00 b | |
| G2 | Cut | 100 a | 100 a | 100 a | 0.92 a | 0.92 a | 1.00 a |
| Perforated | 100 a | 100 a | 100 a | 0.79 a | 0.58 a | 0.83 a | |
| Intact | 17 b | 17 b | 0 b | 0.17 b | 0.17 b | 0.00 b | |
| Parameter | G1 | G2 | G3 |
|---|---|---|---|
| Conidiomata (µm) | |||
| PDA | 74-220-474 (89.0) aA | 172-301-393 (54) bA | 22-107-350 (99) cA |
| MEA | 24-79-175 (39.4) aB | 26-70-119 (21) aB | 24-52-109 (20) bB |
| CM | 278-501-757 (114) aC | 174-391-643 (122) bA | 206-413-633 (103) bC |
| Conidia Length (µm) | |||
| PDA | 4.8-6.3-8.1 (0.8) aA | 5.4-6.9-8.3 (0.7) bA | 4.9-6.7-8.1 (0.7) bA |
| MEA | 4.4-5.7-7.2 (0.7) aB | 5.2-7.0-8.8 (0.8) bA | 5.3-6.7-8.1 (0.7) cA |
| CM | 4.9-6.4-7.6 (0.6) aA | 5.8-6.9-8.3 (0.6) bA | 4.9-6.7-8.7 (0.9) bA |
| Conidia Width (µm) | |||
| PDA | 2.0-2.6-3.2 (0.3) cAB | 1.9-2.8-3.4 (0.3) bA | 2.3-3.0-4.0 (0.4) aA |
| MEA | 2.2-2.7-3.1 (0.2) aA | 2.2-3.1-3.8 (0.4) bB | 2.1-2.9-3.6 (0.4) cA |
| CM | 1.8-2.5-3.2 (0.3) aB | 2.3-3.1-4.1 (0.4) bB | 1.7-2.3-3.0 (0.3) cB |
Disclaimer/Publisher’s Note: The statements, opinions and data contained in all publications are solely those of the individual author(s) and contributor(s) and not of MDPI and/or the editor(s). MDPI and/or the editor(s) disclaim responsibility for any injury to people or property resulting from any ideas, methods, instructions or products referred to in the content. |
© 2023 by the authors. Licensee MDPI, Basel, Switzerland. This article is an open access article distributed under the terms and conditions of the Creative Commons Attribution (CC BY) license (https://creativecommons.org/licenses/by/4.0/).
Share and Cite
Possamai, G.; Dallemole-Giaretta, R.; Gomes-Laranjo, J.; Sampaio, A.; Rodrigues, P. Chestnut Brown Rot and Gnomoniopsis smithogilvyi: Characterization of the Causal Agent in Portugal. J. Fungi 2023, 9, 401. https://doi.org/10.3390/jof9040401
Possamai G, Dallemole-Giaretta R, Gomes-Laranjo J, Sampaio A, Rodrigues P. Chestnut Brown Rot and Gnomoniopsis smithogilvyi: Characterization of the Causal Agent in Portugal. Journal of Fungi. 2023; 9(4):401. https://doi.org/10.3390/jof9040401
Chicago/Turabian StylePossamai, Guilherme, Rosangela Dallemole-Giaretta, José Gomes-Laranjo, Ana Sampaio, and Paula Rodrigues. 2023. "Chestnut Brown Rot and Gnomoniopsis smithogilvyi: Characterization of the Causal Agent in Portugal" Journal of Fungi 9, no. 4: 401. https://doi.org/10.3390/jof9040401
APA StylePossamai, G., Dallemole-Giaretta, R., Gomes-Laranjo, J., Sampaio, A., & Rodrigues, P. (2023). Chestnut Brown Rot and Gnomoniopsis smithogilvyi: Characterization of the Causal Agent in Portugal. Journal of Fungi, 9(4), 401. https://doi.org/10.3390/jof9040401

